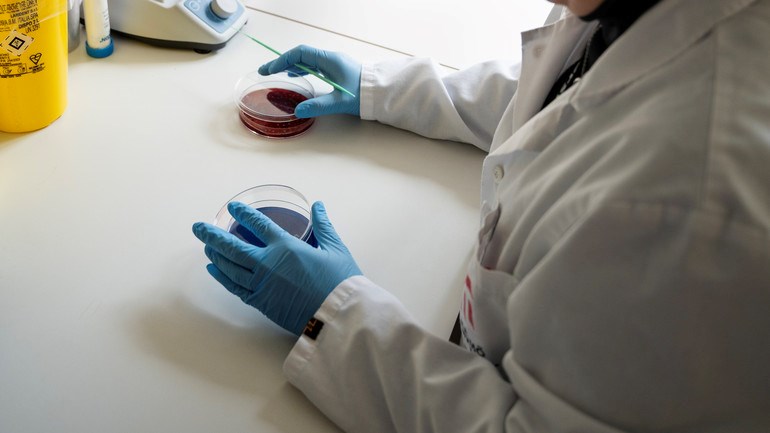
Forskare i labbmiljö.

Nya verktyg i arsenalen för att bekämpa orala sjukdomar
I sin avhandling konstaterar Olivia Aherne och hennes kollegor att stabiliserad hypokloritsyra (sHOCl) är effektivt för att döda biofilmbakterier.
Tandlossningssjukdom och karies är två av världens vanligaste icke-smittsamma sjukdomar. De orsakas av uppbyggnaden av tjocka beläggningar av orala bakterier på tänderna. I sin avhandling har Olivia Aherne fokuserat på ett antimikrobiellt medel som skulle kunna användas som en ny aktiv ingrediens i plackbekämpningen.
Tandborstning och tandtråd räcker inte alltid för att avlägsna plack i munnen. Det innebär att det finns en efterfrågan på nya antiplackmedel. Olivia Aherne har undersökt om stabiliserad hypokloritsyra (sHOCI) kan användas som ett kompletterande verktyg i plackbekämpningen.
– I en labbmiljö har jag försökt skapa biofilmer som efterliknar plack som orsakar karies och tandlossningssjukdom. Jag har sedan behandlat dessa biofilmer med det här antimikrobiella medlet för att se om det är effektivt för att ta död på bakterierna, säger hon.
I sin avhandling konstaterar Olivia Aherne och hennes kollegor att sHOCl är effektivt för att döda biofilmbakterier, även i låga koncentrationer.
Viktigt att skapa relevanta sjukdomsmodeller
– Generellt är biofilmer ett stort problem inom medicin eftersom de ökar vårdtiderna på sjukhus, liksom bakteriernas resistens mot antimikrobiella medel. Förhoppningsvis kan sHOCl ha en positiv inverkan i framtidens behandlingar inom flera områden.
Ett annat fokus i avhandlingen var att skapa relevanta sjukdomsmodeller. Enligt Olivia Aherne används oftast förenklade modeller med ensamma bakteriearter som växer i en näringsrik lösning. Men de flesta sjukdomar, särskilt i munnen, orsakas av bakteriesamhällen med många olika arter i biofilmer som är mycket mer motståndskraftiga än enstaka celler.
– Det är väldigt lätt att angripa enstaka celler, men när de befinner sig i ett stort kluster är det mycket svårare. Det var därför jag fokuserade på att skapa dessa biofilmsmodeller med blandade samhällen. För mig var det en viktig aspekt av avhandlingen; att bättre återspegla de sjukdomar vi är intresserade av.
Om avhandlingen
Olivia Aherne disputerar den 19 december. Hennes avhandling finns digitalt tillgänglig:
Läs Olivia Ahernes avhandling i Diva.
Läs mer om forskningen: